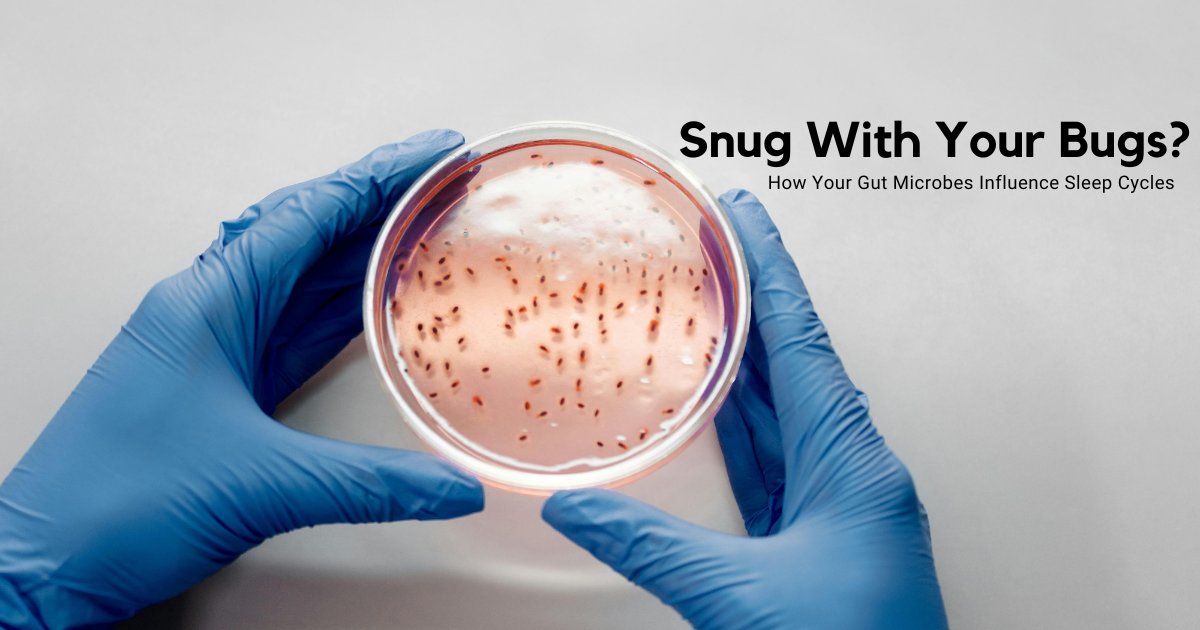

The bacteria living in your gut and mouth may be doing more than just aiding digestion—they could actually be influencing how well you sleep. Scientists are now uncovering evidence that these microscopic organisms play a vital role in regulating sleep cycles and overall rest quality.
As you drift off to bed each night, your body becomes a hub of unseen activity. Trillions of microbes are busy working inside and around you. While that thought might sound unsettling, research suggests these tiny organisms could be the key to better, deeper sleep.
Experts are now exploring how targeting the gut microbiome with probiotics, prebiotics, and diet changes might help treat insomnia, restless nights, and disrupted circadian rhythms.
#1Emerging studies suggest that the microbiota—the vast communities of bacteria.
viruses, and fungi living in and on our bodies—may play a critical role in shaping how well we sleep. Depending on the unique makeup of each person’s microbial ecosystem, sleep quality can either improve or decline.
Intriguingly, this discovery could open new doors for addressing sleep disorders linked to disrupted circadian rhythms. Instead of relying solely on traditional sleeping pills for chronic insomnia, the future might involve using probiotics or “friendly” bacteria to promote rest, or even to manage conditions like obstructive sleep apnea, where normal breathing is interrupted during sleep. This would give a whole new meaning to the phrase “sleep hygiene.”
“For a long time, the predominant theory was that sleep disorders disrupt the microbiome,” explains Jennifer Martin, a professor at the University of California, Los Angeles, and board member of the American Academy of Sleep Medicine. “But the latest evidence suggests the relationship actually works both ways.”
At a recent sleep science conference, new research added to the growing body of evidence. It revealed that teenagers and young adults with greater microbial diversity in their mouths tended to sleep longer, strengthening the case that our microbiomes may be directly influencing rest.
#2Research has also shown that people with medically diagnosed insomnia have lower bacterial diversity in their guts compared to normal sleepers.
something typically linked to a less healthy immune system and impairments in dealing with fats and sugars, which can lead to an increased risk of diabetes, obesity and heart disease. Another study, in which 40 people volunteered to wear sleep trackers for a month and have their gut microbiome analysed, also found that poor sleep quality correlated with a less diverse population of gut microbes.
Plus, people with social jetlag – where their sleep patterns during the working week and weekend vary enormously – had significantly different gut microbiomes to those whose sleep patterns did not vary much, according to data analysed by UK health-tech company Zoe.
"Circadian rhythm disruption occurs in people who stay up later and sleep in on the weekends, those who work long hours, like first responders, police and security, paramedics and the military, and in people who eat too close to bedtime," says Kenneth Wright, a professor of integrative physiology at the University of Colorado Boulder in the US. "This can cause gastrointestinal disturbances and metabolic diseases, which are common for example in shift workers, and a disturbed microbiome may play a role."
#3It's possible that individuals with disrupted sleep tend to follow less healthy diets.
which then impacts their microbiome, suggests Sarah Berry, a nutritional sciences professor at King's College London and chief scientist at Zoe. She cites other research not conducted by Zoe that found that short sleepers tend to subconsciously increase their sugar intake.
"Part of the theory behind this is that when you've had a bad night's sleep, the reward centres in your brain are heightened the next day, and so you seek out that quick fix," she says. "Your brain is kind of tricking you into feeling, 'Ok, I need refined carbohydrates', to get that quick burst of energy."
#4Certain bacteria may actively alter the quality of the sleep we get by shifting our circadian rhythms
But changing dietary patterns in response to sleep deprivation is not the whole story. Berry and her colleagues found nine species that were greater in abundance and eight that were less abundant in people with social jet lag compared to those without this variation in sleep patterns. But they found that diet appeared to only account for changes in abundance for four of these microbe species.
Jaime Tartar, a professor of psychology and neuroscience at Nova Southeastern University in Florida who was not involved in the Zoe study, says she has become increasingly convinced that certain microbes play a direct role in sleep. She cites Firmicutes, one of the most dominant taxonomic groups of bacteria found in the gut. In tests where Tartar and her colleagues monitored the sleep and tested the gut microbes of 40 men, they found 15 different groups of Firmicutes bacteria that correlated with a number of sleep metrics in varying ways. "We don't have all the answers right now, but it certainly seems that some can improve sleep and others can impair sleep," she says.
In some cases, sleep disruptions might actively drive shifts in these microbial populations through impairing the immune system and its ability to regulate microbes, which could in turn increase the likelihood of longer-term sleep problems.
But researchers including Tartar and Martin suggest that some sleep problems could also be initiated by microbial imbalances in the gut or mouth. They believe that certain bacteria may actively alter the quality of the sleep we get by shifting our circadian rhythms – the internal body clock that governs our sleep – and altering our food intake, which also impacts the kip we get.
#5Some evidence for this comes from a series of studies involving so-called faecal transplants.
In one 2024 study, scientists transplanted faeces – along with the gut microbes it contained – from humans and implanted it into the intestines of mice. Rodents who received faeces from people suffering from jetlag and insomnia developed insomnia-like behaviours, becoming more awake during their typical sleeping hours. In another study where mice received a series of gut microbes from humans before, during, and after recovery from jetlag, the transplantation of microbes during the jetlag phase saw them gain weight and struggle to control their blood sugar.
A number of small-scale studies in humans by researchers in China have shown that faecal transplants could help to improve the sleep of patients suffering from chronic insomnia and sleep disorders. Of course, it's worth remembering that many aspects of sleep involve psychological factors, so it is possible that receiving a transplant led patients to change their mindset in a way that allowed them to sleep more soundly. A randomised, double-blind clinical trial will be needed to test the efficacy properly, the researchers say.
#6There’s growing evidence that the gut microbiome could directly influence how well we sleep.
Diet is a key factor. In one study, 15 healthy young men followed a high-fat, high-sugar diet for just a week. The results showed noticeable changes in their brain’s electrical activity during deep sleep—though researchers caution that the small sample size makes it difficult to draw firm conclusions. Similarly, another experiment found that volunteers who received antibiotics experienced a reduction in non-REM sleep—the critical stage when the body repairs itself and consolidates memory and learning. However, not all antibiotics had the same effect, and the study was also small.
Beyond diet, changes in gut microbial balance may affect the production of essential chemicals that microbes release when breaking down food. These include key neurotransmitters such as GABA (gamma-aminobutyric acid), dopamine, norepinephrine, and serotonin, as well as short-chain fatty acids like butyrate—all of which play critical roles in sleep regulation.
“If those microbes decline, their chemical influence on the brain also diminishes,” explains neuroscientist Jaime Tartar. At the same time, other microbes thrive on saturated fats and sugars, producing inflammatory molecules that may disturb sleep. Some of these inflammatory byproducts, such as specific bile acids, are believed to disrupt the brain’s circadian rhythms, making restful sleep harder to achieve.
#7Scientists are now looking beyond the gut and exploring how the oral microbiome may also affect sleep.
According to Jennifer Martin of UCLA, poor diets and poor dental health can fuel microbial imbalances that trigger inflammation. This heightened inflammation may increase the risk of obstructive sleep apnea (OSA)—a condition where the throat muscles relax during sleep, blocking airflow and disrupting normal breathing.
An imbalanced microbiome may contribute to airway narrowing, elevated stress hormones, and systemic inflammation—all of which can disturb sleep over time. On the flip side, gut microbes naturally produce neurotransmitters like serotonin, dopamine, and GABA, which help regulate circadian rhythms and support restorative sleep.
This has led researchers to investigate whether probiotics and prebiotics could offer new treatment options for sleep disorders. One study on 94 medical students found that the probiotic Lactobacillus casei Shirota improved sleep during stressful periods compared to a placebo. Similarly, the BIOME study by Zoe tested nearly 400 adults with a prebiotic blend of over 30 plant-based ingredients, a probiotic (Lactobacillus rhamnosus), or a placebo. Those taking the prebiotic blend reported better sleep quality than the control group.
However, experts caution that more large-scale, clinical trials are needed. Proven therapies like cognitive behavioral therapy (CBT-I) and prescribed medications remain the gold standard for treating insomnia and sleep apnea. Still, Martin notes that probiotics may hold promise for patients who don’t respond well to CBT-I or prefer to avoid sedative medications.
“Circadian rhythm disruption is incredibly common—from shift workers to frequent travelers,” says Kenneth Wright of the University of Colorado Boulder. “If microbiome therapies prove effective, they could benefit millions struggling with insomnia, jet lag, or sleep apnea.”
It’s a field still in its early stages, but if microbes can truly help us sleep better, they may redefine what we call sleep hygiene.